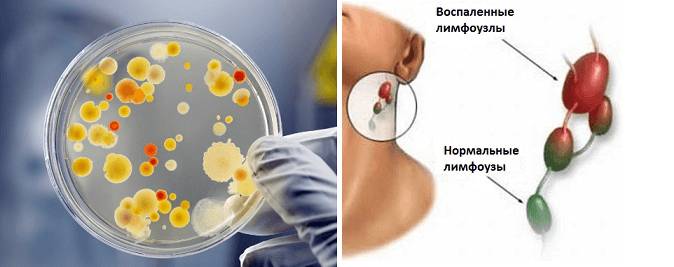
Фото болезни

Любая болезнь – это всегда плохо, особенно если она настолько «коварная», что маскируется под другое заболевание. Как раз таки таким недугом является – дифтерия у детей симптомы и лечение профилактика которой описаны ниже.
Что такое дифтерия у детей
Заболевание дифтерия – это тяжелый инфекционный недуг, поражающий лор органы (носоглотка, гортань, бронхи), реже кожу и половые органы. Возбудитель дифтерии – грамположительные бактерии рода коринебактерий (Corynebacterium diphtheriae). Передается здоровому человеку возбудитель дифтерии чаще воздушно-капельным путем от заболевшего, и реже контактно-бытовым и пищевым путем.
Формы дифтерии подразделяются по локализации и течению заболевания:
- Дифтерия ротоглотки (локализованная, распространенная, субтоксическая и токсическая);
- круп (локализованный, распространенный, нисходящий);
- миокардит.
Дифтерия ротоглотки самый распространенный вид инфекции. Дифтерия ротоглотки характеризуется появлением специфических фибриновых пленок, под которыми размножаются микробы и при попытке удалить экссудативное воспаление фибринозного характера образуются язвы. Дифтерия ротоглотки поддается лечению, благодаря чему фибриновая пленка растворяется и ткани, которые находились под ней, постепенно восстанавливаются.
Также формы дифтерии могут перейти в опасную и самую тяжелую форму. Это происходит из-за поражения дифтерией гортани, сопровождающейся дыхательными расстройствами способными повлечь за собой летальный исход.
Врачи отмечают, что дифтерия у детей проявляется различными симптомами, включая боль в горле, затрудненное дыхание, повышение температуры и образование налета на миндалинах. Эти признаки могут развиваться быстро, и при отсутствии своевременного лечения заболевание может привести к серьезным осложнениям. Лечение дифтерии обычно включает применение противодифтерийной сыворотки и антибиотиков, что позволяет эффективно справиться с инфекцией. Профилактика остается ключевым аспектом в борьбе с заболеванием: вакцинация детей в соответствии с национальным календарем прививок значительно снижает риск заражения. Врачи подчеркивают важность регулярных осмотров и своевременного обращения за медицинской помощью при первых симптомах.

Симптомы и причины дифтерии у детей
Все формы дифтерии имеют схожие симптомы. Так дифтерия ротоглотки и других органов (зева, глаз, половых органов) проявляется общей слабостью, невысокой температурой тела 37,5 градусов, тахикардией.
- Появление фибриновых, сероватых пленок на миндалинах (которые можно увидеть на фото) характерно для поражения ротоглотки. Сильный кашель, расстройства дыхания, а также отек шеи характерен для инфицирования гортани. Появление сероватого налета или незаживающих ран может быть дифтерией кожи.
- Если дифтерией поражается зев, то симптомы часто путают с простудой. Поскольку основные симптомы это – покраснение слизистой горла, налет, увеличиваются миндалины и появляется неприятное чувство при глотании. Дифтерия гортани у детей может стать следствием запущенности инфекции и не оказания своевременных мер и лечения.
- Точнее понять каковы симптомы дифтерии можно посмотрев на фото пораженного горла, но точный диагноз сможет поставить только врач.
- Страшна не сама Corynebacterium diphtheriae, а ее токсин, который попадает в органы (сердце, почки, дыхательные пути) и отравляет организм изнутри.
Дифтерия. Симптомы, признаки и методы лечения
https://youtube.com/watch?v=YVUYwkzdWC8
Патогенез во время дифтерии у детей
Порой бывает сложно обнаружить признаки дифтерии у ребенка, ребенок может перенести и легкую форму инфекции, которая не разовьется в осложнение, а пройдет как банальное ОРВИ. Грамположительные бактерии оказывают токсическое действие на организм ребенка. Эти экзотоксины проникая в организм могут попасть в лимфатические пути, при этом отекает слизистая оболочка и образуется «бычья шея» что можно подробно увидеть на фото.
Основные осложнения после дифтерии у детей напрямую зависят от степени поражения экзотоксинами тканей. Экзотоксины попадая в кровь поражают надпочечники, сердце, мышечные волокна и почки. Последствия дифтерии могут быть вплоть до некроза, миокардита, полиневрита и т.д.
Дифтерия — это острое инфекционное заболевание, которое может представлять серьезную угрозу для здоровья детей. Симптомы начинаются с высокой температуры, слабости и боли в горле, что может привести к затрудненному дыханию из-за образования налета на миндалинах. Родители часто отмечают, что у детей появляется характерный “громкий” кашель и хрипота. Лечение включает применение антибиотиков и противодифтерийной сыворотки, что требует немедленного обращения к врачу. Профилактика заключается в вакцинации, которая защищает детей от этого опасного заболевания. Важно следить за календарем прививок и вовремя делать необходимые уколы. На фото, представленных в интернете, можно увидеть, как выглядит дифтерийный налет, что помогает родителям быть внимательнее к симптомам у своих детей.
Диагностика и профилактика дифтерии у детей
Диагноз дифтерии может поставить только врач. Как правило, он обращает внимание на такие характерные проявления как:
- наличие фибриновой пленки при осмотре гортани, ротоглотки и носа;
- небольшое покраснение слизистой;
- затрудненность дыхания, потеря голоса;
- увеличенные лимфатические узлы;
Лабораторная диагностика дифтерии
Если ярких клинических проявлений не наблюдается, то необходим лабораторный анализ или бактериоскопический мазок.
Чтобы выявить антитела в крови применяются специальные серологические методы исследования, такие как:
- реакция преципитации (РП) в полужидком геле агара (двойная иммунодиффузия по Оухтерлони);
- реакция непрямой гемагглютинации (РНГА);
- реакция пассивной гемагглютинации (РПГА);
- иммуноферментный анализ (ИФА);
- радиоиммунологический анализ (РИА) и т.д.
Также сдается обыкновенный общий анализ крови, для выявления инфекции. И бактериальный посев пробы мазка.
Чтобы ваш малыш не заболел нужно своевременно сделать прививку от дифтерии, прививка от дифтерии хоть и не дает 100% защиты от этой инфекции, но хотя бы защищает организм от дифтерийных палочек способных усугубить, и осложнить течение болезни.
Чтобы предупредить болезнь вводиться вакцина дифтерия столбняк и коклюш (АКДС). Прививка против дифтерии и столбняка вводится впервые крохам в три месяца отроду. Причем она является наиболее трудно переносимой вакциной и имеющие побочные действия. Не стоит переживать если побочные действия в виде температуры и беспокойства у крохи, пройдут в течение 2 суток, если же симптомы не проходят нужно обращаться к врачу.
- Вакцина от дифтерии называется АКДС, ребёнок должен ее перенести четыре раза до исполнения ему двух лет. Периоды, когда нужно проводить иммунизацию у детей следующие: 3 месяца, 4,5 месяца, 6 месяцев и 1,5 года. Такой «столбнячный укол» переноситься детьми тяжело, особенно впервые. Но основной источник, провоцирующий побочные действия имеет «К» компонент вакцины, т.е. коклюш. По этой причине, дабы минимизировать побочные проявления от препарата, для ревакцинации возможно делать прививку АДС-м.
- Вакцинация против дифтерии – это самая лучшая профилактика заболевания у детей. Часто родителей интересует вопрос можно ли мыться после прививки от дифтерии. Ответ прост, подождите сутки, а потом можете мочить место укола. Сам укол карапузам вводят в ногу (бедро), малышам постарше и взрослым вакцина вводиться в плечо внутримышечно.
Родители, прививающие в правильное время своих малышей, оберегают их от этого ужасного недуга. Прививки должны быть сделаны вовремя, и родители должны также проходить процедуру ревакцинации каждые 10 лет чтобы обезопасить не только своих детей, но и себя, в том числе.
Лечение ротоглотки и гортани
Насмотревшись множество фотографий, особенно фото пораженных пленками слизистых оболочек ротоглотки, понимаешь что уход за ребенком, подцепившего эту заразу – это тяжелая ноша, от которой необходимо избавиться в кратчайшие сроки, стараясь не доводить распространение инфекции до тяжелых последствий.
Чтобы вылечить пораженную вирусом ротоглотку и гортань, нужно ввести специальную сыворотку, под названием ПДС желательно в первые 2 дня болезни. Также совместно с этой сывороткой проводят терапию антибиотиками. Перед тем как вводить ПДС малышу следует сделать анализ на ее переносимость (пробу). Начинают лечить этой сывороткой даже до окончательного подтверждения лабораторных анализов на наличие экзотоксинов.
- Терапия антибиотиками проводится для предотвращения тяжелых последствий заражения, в особенности от пневмонии. Совместное лечение с ПДС показано при любой стадии заболевания. В дополнении можно применять назально иммуномодулирующие и детоксицирующие препараты типа полиоксидоний, а также полоскание горла и в некоторых случаях глюкокортикостероиды.
- Также отоларинголог должен провести санацию (процедура очистки органа) пораженных участков носоглотки. В дополнение должна проводиться иммуноукрепляющая терапия при помощи витаминов и минералов, и обязательно пастельный режим при тяжелом течении заболевания. Некоторые препараты имеют противопоказания. Поэтому лечение должен назначить только врач.
- Обычно локализованное поражение гортани и ротоглотки легко поддается лечению, и дает возможность избежать тяжелых последствий. Как правило, однократного введения ПДС и недельной терапии антибиотиками (в особенности эритромицином) бывает достаточно, чтобы полностью излечиться от недуга.
Помните, что, переболев данной заразой стойкого иммунитета у организма не вырабатывается. Это означает что возможно повторное заражение инфекцией. Для того чтобы избежать тяжелых форм заболевания, проводите постоянную ревакцинацию всей семьей. И тогда возможно, вы никогда не вспомните об этой страшной и коварной «болячке».
К каким докторам следует обращаться если у ребенка дифтерия
Если ребенок все же заболел дифтерией нужно обращаться к специализированному врачу. Такими являются отоларинголог и инфекционист. Лор проведет клиническое обследование для выявления внешних симптомов недуга, а инфекционист будет проводить лабораторные исследования полученных анализов.
Доктор Комаровский: дифтерия и столбняк
Доктор Комаровский советует в любом случае проводить четырехразовую вакцинацию детишкам. Даже если по каким-либо причинам месячные перерывы между вакцинацией были нарушены (болезнь, температура), то это не повод отказывать от прививки вовсе.
Также известный педиатр говорит о том, что самостоятельно отличить «эту коварную заразу» от ангины практически невозможно, поскольку ее не сопровождает высокая температура. А температура 37,2-38 может быть и при ОРВИ. Комаровский утверждает, что, пройдя вакцинацию, человек будет защищен на 95% от «коварной заразы» и в 100% выработается иммунитет к столбняку.
Еще главный педиатр страны настаивает на ревакцинации взрослых каждые десять лет, поскольку даже если вы и заразитесь, то инфекция будет протекать легко, и вы не будете нуждаться в лечении сывороткой (ПДС).
Дифтерия и столбняк – Школа доктора Комаровского

Вопрос-ответ
Как понять, что у ребенка дифтерия?
Чтобы заподозрить дифтерию у ребенка, обратите внимание на такие симптомы, как боль в горле, затрудненное глотание, высокая температура, отек шеи и наличие сероватого налета на миндалинах или задней стенке горла. При появлении этих признаков необходимо немедленно обратиться к врачу для диагностики и лечения.
Какой антибиотик убивает дифтерию?
При всех тяжелых формах дифтерии назначают пенициллин по 1 млн ЕД 4—6 раз в сутки в течение 5—7 дней. При других формах — эритромицин или тетрациклин. Локализованная дифтерия ротоглотки (островчатая). Первоначальная доза ПДС составляет 10—15 тыс.
Как отличить дифтерию от ОРВИ?
Первые симптомы заболевания дифтерией очень сходны с признаками ОРВИ: незначительно повышается температура, часто не выше 38 °С, появляется небольшая боль в горле. Родителей должно насторожить то, что насморк у ребенка отсутствует.
Советы
СОВЕТ №1
Обратите внимание на ранние симптомы дифтерии, такие как боль в горле, затрудненное дыхание и налет на миндалинах. При их появлении немедленно обратитесь к врачу для диагностики и начала лечения.
СОВЕТ №2
Регулярно проводите вакцинацию детей против дифтерии. Вакцинация является наиболее эффективным способом профилактики заболевания и должна проводиться в соответствии с национальным календарем прививок.
СОВЕТ №3
Обеспечьте своему ребенку здоровый образ жизни, включая сбалансированное питание и физическую активность. Это поможет укрепить иммунную систему и снизить риск инфекционных заболеваний, включая дифтерию.
СОВЕТ №4
Следите за гигиеной в семье: регулярно мойте руки, избегайте контакта с больными людьми и не забывайте о чистоте игрушек и предметов, с которыми играет ваш ребенок.